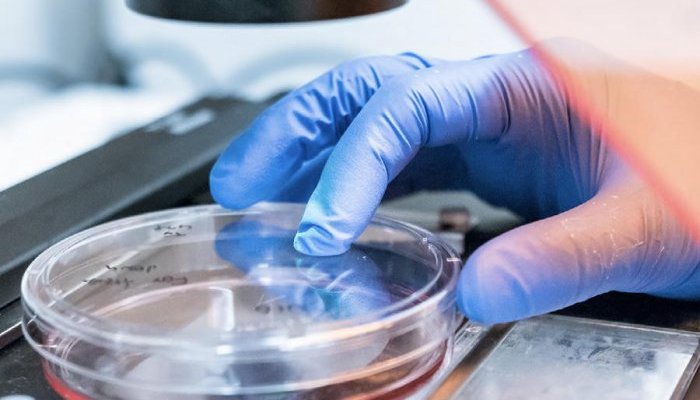

The French-based specialist in lipid chemistry and plant extraction, has developed 3D scaffold-free microtissues to mimic in vitro an elastic tissue, which is responsible for intrinsic elastic properties of the dermis. Indeed, explained Gattefossé in a statement: “The 3D bioengineered skin substitutes currently available on the market are still defective models to study skin elasticity. Indeed, they contain exogenous and artificial matrices that bias the measurement of biomechanical properties in the reconstructed tissue”.
3D scaffold-free spheroids
When it comes to analyzing the biomechanical properties of the skin, the exogenous and artificial supports that serve as a matrix for these skin substrates bias any measurement. However, the deterioration of the organization and functionality of dermal elastic fibers is one of the main causes of age-related skin sagging, which makes them a preferred target for cosmetic anti-aging strategies.
To develop the new advanced models, Gattefossé used the 3D scaffold-free spheroids, which takes advantage of the ability of cells to secrete their own extracellular matrix.
This technology enabled Gattefossé to produce in vitro hundreds of 3D microtissues within a few days only using dermal fibroblasts aggregated in ultra-low affinity plates.
Cutting-edge analytical techniques
To accurately evaluate the elasticity of such skin microtissues, and the efficiency of cosmetic active ingredients, Gattefossé relied on BioMeca’s expertise and state-of-the-art technologies.
The elastic modulus (or Young modulus) was thus measured using Atomic Force Microscopy (AFM) and the elastic fibers were visualized by Second Harmonic Generation (SHG) imaging microscopy. Gattefossé and BioMeca thus demonstrated that the 3D spheroid microtissue is a relevant and reliable model with a complex organization, comprising a dense, mature elastic fiber network sufficiently extensive to mimic in vitro dermal elastic mechanics.
“Second Generation Harmonic microscopy highlights fibers network while Atomic Force Microscopy reveals tissue stiffness in both imaging and mechanically manipulating biological structures near physiological conditions overtime,” underlined the co-Founder of BioMeca, Julien Chlasta.
This investigative approach has been featured at the 31st IFSCC Congress, in Yokohama late in 2020.
“By combining two cutting-edge analytical techniques, i.e., second harmonic generation (SHG) microscopy and atomic force microscopy (AFM), we have been able to accurately correlate both the presence and amounts of elastic fibers with elastic properties of microtissues, thus evidencing that newly formed elastic fibers were functional,” said Dr. HDR Nicolas Bechetoille, Skin Biology Research Manager at Gattefossé.
This advanced 3D model has been used to measure the efficacy of EleVastin a novel active ingredient developed by Gattefossé, fighting against age related loss of skin elasticity. More to come in April 2021.